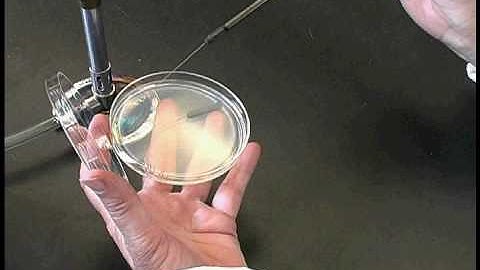
Micro eGuide - Streak Plate Technique

⬇ DOWNLOAD NOW
Kalau muncul iklan pop-up, tutup lalu klik tombol kembali
Download lagu Streak Plate Test and its Procedures - Virtual Interactive Laboratory Experiment secara gratis hanya untuk keperluan promosi. Dukung artis favorit kamu dengan membeli musik original di iTunes atau platform resmi lainnya.
 Lab technique microbiology: Streak plate method
Lab technique microbiology: Streak plate method
 The Best Virtual Streak Plate(Virtual Interactive Bacteriology Laboratory)
The Best Virtual Streak Plate(Virtual Interactive Bacteriology Laboratory)
 Making a Streak Plate
Making a Streak Plate
 Virtual Streak Plate Test
Virtual Streak Plate Test
 Streak Plate Test Simulation
Streak Plate Test Simulation
 Streak Plate Tutorial | Hands-On Labs
Streak Plate Tutorial | Hands-On Labs
 Streak Plating
Streak Plating
Micro eGuide - Streak Plate Technique
Micro eGuide - Streak Plate Technique